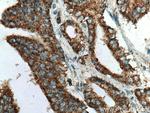
TM7SF2 Antibody in Immunohistochemistry (Paraffin) (IHC (P))

Search
Proteintech
TM7SF2 Polyclonal Antibody
{{$productOrderCtrl.translations['antibody.pdp.commerceCard.promotion.promotions']}}
{{$productOrderCtrl.translations['antibody.pdp.commerceCard.promotion.viewpromo']}}
{{$productOrderCtrl.translations['antibody.pdp.commerceCard.promotion.promocode']}}: {{promo.promoCode}} {{promo.promoTitle}} {{promo.promoDescription}}. {{$productOrderCtrl.translations['antibody.pdp.commerceCard.promotion.learnmore']}}
产品信息
12033-1-AP
种属反应
已发表种属
宿主/亚型
分类
类型
抗原
偶联物
形式
浓度
规格
纯化类型
保存液
内含物
保存条件
运输条件
产品详细信息
Immunogen sequence: APVSALAPG GNSGNPIYDF FLGREVNPRI CFFDFKYFCE LRPGLIGWVL INLALLMKEA ELRGSPSLAM WLVNGFQLLY VGDALWHEEA VLTTMDITHD GFGFMLAFGD MAWVPFTYSL QAQFLLHHPQ PLGLPMASVI CLINAIGYYI FRGANSQKNT FRKNPSDPRV AGLETISTAT GRKLLVSGWW GMVRHPNYLG DLIMALAWSL PCGVSHLLPY FYLLYFTALL VHREARDERQ CLQKYGLAWQ EYCRRVPYRI MPYIY (155-418 aa encoded by BC012857)
靶标信息
TM7SF2 is involved in the conversion of lanosterol to cholesterol.
仅用于科研。不用于诊断过程。未经明确授权不得转售。
生物信息学
蛋白别名: 3-beta-hydroxysterol Delta (14)-reductase; Another new gene 1 protein; C-14 sterol reductase; C14SR; delta(14)-sterol reductase; Delta(14)-sterol reductase TM7SF2; Delta-14-SR; LBR paralog; Putative sterol reductase SR-1; Sterol C14-reductase; Transmembrane 7 superfamily member 2; unnamed protein product
基因别名: 3110041O18Rik; ANG1; C14SR; Dhcr14; DHCR14A; NET47; TM7SF2
UniProt ID: (Human) O76062, (Mouse) Q71KT5
Entrez Gene ID: (Human) 7108, (Mouse) 73166, (Rat) 293688